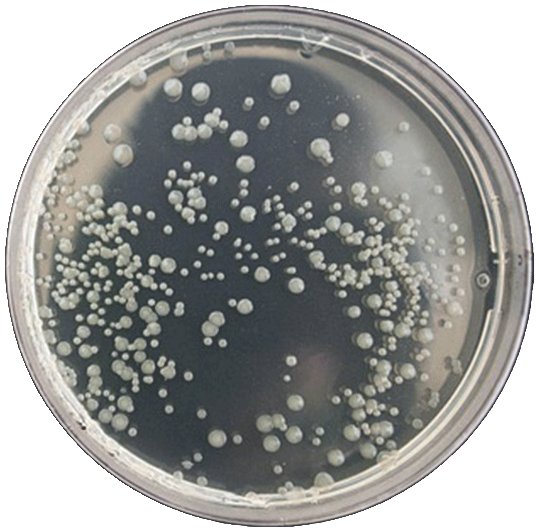

MYCOSCOPE
THE PROBLEM
In the next 20 to 30 years, spore-related infections are expected to increase significantly. Fungal spores are common in agricultural settings.
Although they naturally occur in the environment, they can become harmful to humans when they contaminate the soil and crops we consume.
In small amounts, fungal spores are invisible to the naked eye, yet still capable of causing harm.
INTENDED AUDIENCE
The device is targeted towards those in the agricultural, mycology or food safety sectors.